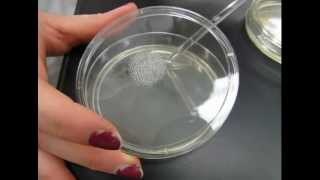

Which Disinfectants Work Best? video
Online izle ve mp4 mp3 formatlarinda yukle

Videonun muddeti: 1:25
Which Disinfectants Work Best? videosu mp4 ve mp3 yuklemek ucun hazirdir
Diqqet! Siz Mp4 yukle ve ya Mp3 yukle duymesine basdiqdan sonra eger sistem sizi reklam sehifesine atarsa o zaman derhal geri qayidib emeliyyati tekrar edin ve faylin yuklemek ucun hazir olmasini gozleyin
Videodan Mp4 Yukle
Videodan Mp3 Yukle-1
Videodan Mp3 Yukle-2
Oxshar Axtarishlar
 Which Disinfectants Work Best?
Which Disinfectants Work Best? You’re Using Disinfectants Wrong. Here’s What You Actually Need to Do.
You’re Using Disinfectants Wrong. Here’s What You Actually Need to Do. Which Disinfectant Works Best?
Which Disinfectant Works Best? Best products to disinfect home
Best products to disinfect home Which is the BEST Toilet Cleaner Disinfectant? Clorox? Lysol? Pinesol? Vinegar Baking Soda Tea Tree?
Which is the BEST Toilet Cleaner Disinfectant? Clorox? Lysol? Pinesol? Vinegar Baking Soda Tea Tree? Which is better: Soap or hand sanitizer? - Alex Rosenthal and Pall Thordarson
Which is better: Soap or hand sanitizer? - Alex Rosenthal and Pall Thordarson Why 70% Alcohol Is a Better Disinfectants Than 100% Alcohol
Why 70% Alcohol Is a Better Disinfectants Than 100% Alcohol Best Disinfectant All Purpose Cleaner -Removes Dirt & Freshens Surfaces
Best Disinfectant All Purpose Cleaner -Removes Dirt & Freshens Surfaces Which Chemical is the Best Disinfectant? (Disinfectant Lore)
Which Chemical is the Best Disinfectant? (Disinfectant Lore)
Video Mp4 Mp3Azwap.Biz
Azwap.Biz 2021-2023

Which Disinfectants Work Best?
Which Disinfectants Work Best? You’re Using Disinfectants Wrong. Here’s What You Actually Need to Do.
You’re Using Disinfectants Wrong. Here’s What You Actually Need to Do. Which Disinfectant Works Best?
Which Disinfectant Works Best? Best products to disinfect home
Best products to disinfect home Which is the BEST Toilet Cleaner Disinfectant? Clorox? Lysol? Pinesol? Vinegar Baking Soda Tea Tree?
Which is the BEST Toilet Cleaner Disinfectant? Clorox? Lysol? Pinesol? Vinegar Baking Soda Tea Tree? Which is better: Soap or hand sanitizer? - Alex Rosenthal and Pall Thordarson
Which is better: Soap or hand sanitizer? - Alex Rosenthal and Pall Thordarson Why 70% Alcohol Is a Better Disinfectants Than 100% Alcohol
Why 70% Alcohol Is a Better Disinfectants Than 100% Alcohol Best Disinfectant All Purpose Cleaner -Removes Dirt & Freshens Surfaces
Best Disinfectant All Purpose Cleaner -Removes Dirt & Freshens Surfaces Which Chemical is the Best Disinfectant? (Disinfectant Lore)
Which Chemical is the Best Disinfectant? (Disinfectant Lore)